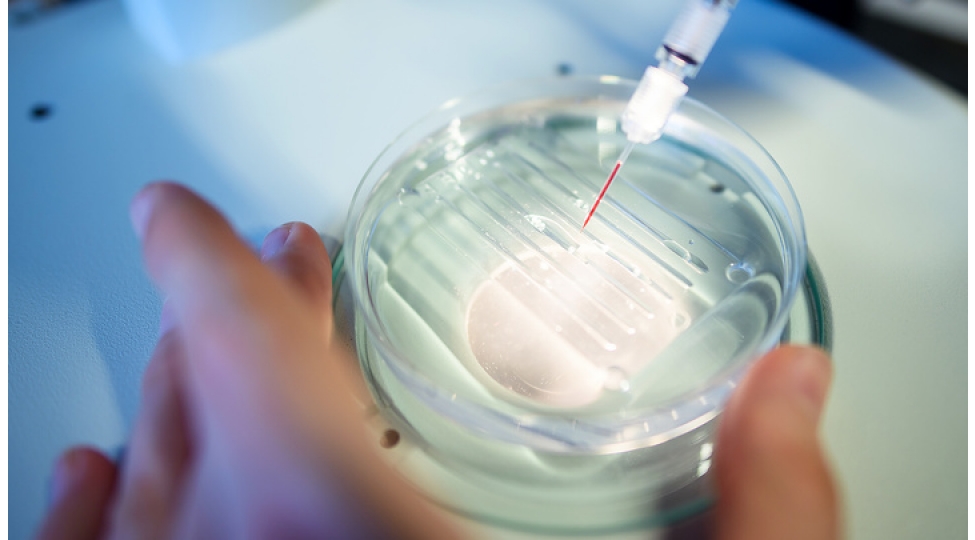
xercheng-yoluxucu-deyil-ancaq-ona-da-virus-sebeb-ola-biler-bioloq

Bu dəhşətli xəstəlik insandan insana keçə bilməz
Bu, yoluxucu xəstəlik deyil. Bu fikri rusiyalı molekulyar bioloq Vladislav Mileiko “Smotrim” platformasına bildirib. “Fakt budur ki, immun sistemi transplantasiya edilmiş orqan və toxumaları rədd etdiyi kimi yad cismin xərçəng hüceyrələrini də məhv edir. Ancaq xərçəngin özü yoluxucu olmasa da, potensial olaraq şişlərin inkişafına səbəb ola biləcək bir virusa yoluxa bilərsiniz”
Məsələn, uşaqlıq boynu xərçənginə cinsi yolla keçən insan papillomavirusu səbəb ola bilər. 130 HPV ştamından 14-ü yüksək onkogen riskə malikdir, onların arasında ən çox 16 və 18-ci növlərə rast gəlinir. “Üstəlik, 25% hallarda bu, ümumiyyətlə, viral infeksiya ilə əlaqəli deyil”,-deyə ekspert vurğulayıb.
Risk altında olanlar vaxtında həkimə müraciət etməlidirlər, xərçəngönü xəstəliklərə tez bir zamanda diaqnoz qoyulur və uğurla müalicə olunur. Bundan əlavə, indi uşaqlar HPV-yə qarşı peyvənd olunmağa başlayıblar və belə peyvəndlə gələcəkdə uşaqlıq boynu xərçəngindən ölüm hallarının köklü şəkildə azalacağına ümidlər var.
Hepatit B və C ilə yoluxmuş insanlarda potensial olaraq qaraciyər xərçəngi inkişaf edə bilər. Epstein-Barr virusu (herpes virusu tip 4) potensial olaraq Berkitta limfomasına və nazofarenks xərçənginə səbəb olur.
Xüsusi bir bakteriya olan “Helicobacter pylori” ilə xroniki infeksiya müəyyən növ mədə xərçənginə səbəb olur. Yetkin insanlarda bu bakteriyaya rast gəlinməsi halları çoxalıb.İmmunitet sistemi “Helicobacter”in öhdəsindən gələ bilmirsə, onun yaratdığı toksinlər mədə selikli qişasını məhv edir, mədə şirəsi onu korroziyaya salmağa başlayır və bu, iltihaba, bəzi hallarda isə mədə xorasına gətirib çıxarır, qarşısı vaxtında alınmadıqda isə xərçəngə çevrilir.
“Bütün hallarda düzgün diaqnoz və müalicə xəstələrə tam sağalmağa kömək edir”, -deyə Mileiko xatırladıb.
Nubar Süleymanova, “İki sahil”